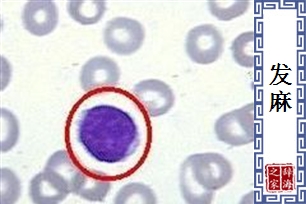
发麻

【发麻】的意思和解释
【发麻】 是什么意思(来源:辞典修订版)
- 感觉麻木。如:「他被父亲罚跪快二小时了,手脚已发麻。」
【发麻】 是什么意思(来源:辞典简编版)
- 身体组织感觉麻木。
【造句】趴在桌上睡,容易使手臂的血液循环不佳而发麻。 - 形容惊悚、害怕。
【造句】电影上的魔鬼扮相十分骇人,令人看了不禁头皮发麻。
【发麻】 图片鉴赏
相关词语
查字典的部份资料来自网络或由网友提供,不保留版权,如有侵权,请与我们联系以从站上删除! 免责声明:本站非营利性站点,以方便网友为主,仅供学习。
Tip:SCCG
